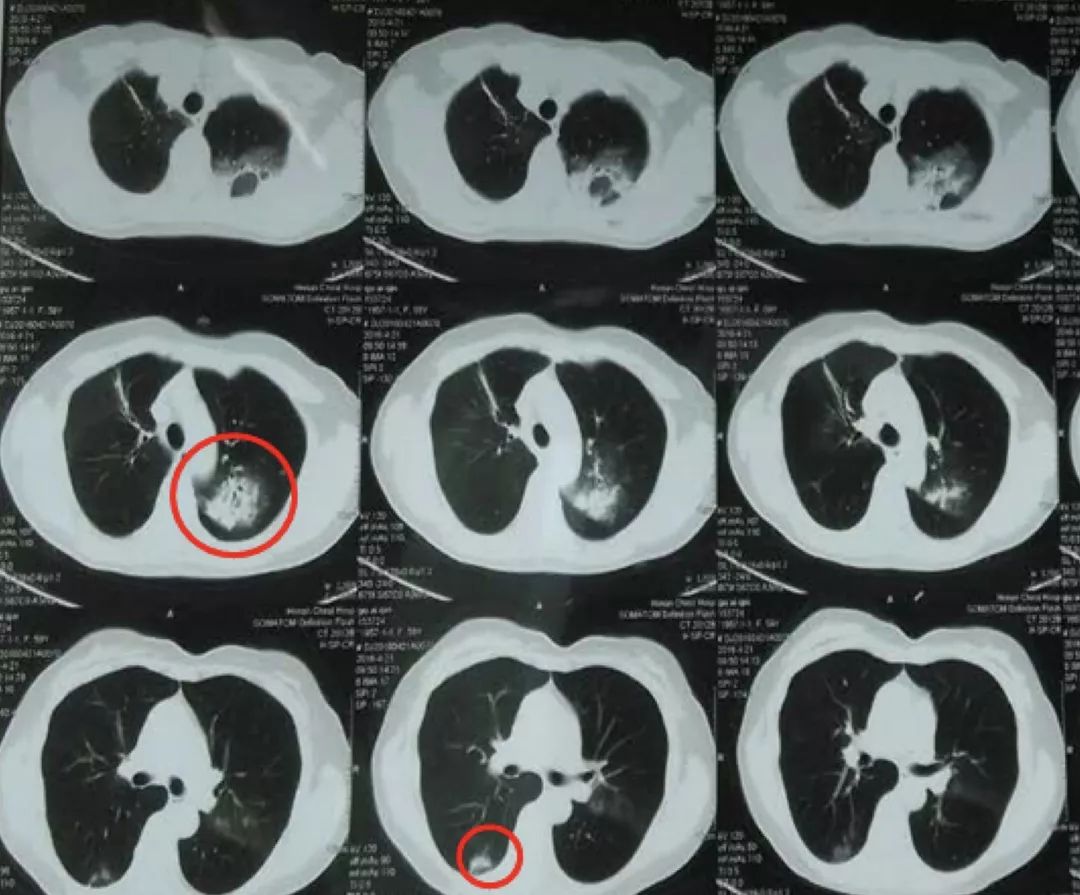
抗感染治疗后效果欠佳，感染非感染？TBLB和肺穿刺病理有哪些提示

推荐语
中年女性,亚急性起病,既往体健,无免疫宿主因素,以发热、咳嗽、咳痰、胸闷起病,外院抗感染治疗20天之后,右上肺病灶吸收差,出院后口服莫西沙星9天,1个月后复查胸部CT,右上肺病灶基本吸收消散,仅遗留少许纤维条索影,但左上肺尖后段及右下肺背段却出现新发团块阴影。迷雾重重之下,该病变首先考虑是感染性病变还是非感染性病变?TBLB和肺穿刺病理给予我们哪些提示作用?如何区分OP的分型以及鉴别要点?
患者,女,62岁, 职业:退休会计,2017年3月5日入院
主诉:发热、咳嗽、咳痰2月,胸闷7天
现病史
2月前患者受凉后出现发热,多为午后,体温波动于36.7~38.0°C,咳嗽,咳痰,为白粘痰,量少,不易咳出,伴盗汗,无畏寒、咯血、胸痛、心悸等不适,按「上呼吸道感染」,口服「罗红霉素胶囊 0.15g 2次/日」抗感染及退热治疗5天,症状无明显缓解,至当地医院行肺CT检查,结果示「右上肺阴影」,以「社区获得性肺炎」收住该院,先后给予阿奇霉素及左氧氟沙星抗感染治疗20天(具体用法不详),咳嗽、咳痰较前缓解,体温波动在37.1~37.3°C,于2017年2月5号复查肺部CT阴影较前有所吸收,出院口服「莫西沙星片 0.4g 1次/日」, 共9天。
7天前无明显诱因体温升至37.8°C,未重视,渐出现胸闷,活动后加重,一般体力活动不受限,与体位无明显关系,复查胸部CT示「双肺阴影」,为进一步诊治,于2017年3月5日入我院,门诊以「社区获得性肺炎」收住我科。
起病以来,神志清,精神可,食欲、睡眠可,两便正常,体重无明显变化。
既往史
无高血压、心脏病史,无糖尿病、脑血管疾病病史,无肝炎、结核、疟疾病史,预防接种史不详,无手术、外伤、输血史,无食物、药物过敏史。
个人史
生于原籍,久居本地,无疫区居住史,无有毒物质接触史,无吸烟、饮酒史。居住环境干燥,无宠物饲养史、粉尘吸入史、花草种植史。
婚育史
婚姻史及月经生育史无特殊。
家族史
父母、3兄弟、1姐妹健康状况良好,无与患者类似疾病,无家族性遗传病史。
体格检查
T:37.5℃ P:90次/分 R:20次/分 BP:120/78mmHg
神志清,精神可,自主体位,营养中等,皮肤潮湿,口唇无紫绀,左上肺语颤稍增强,叩诊浊音,左上肺呼吸音粗,可闻及爆裂音,心、腹查体无明显异常,未见杵状指(趾),双下肢无水肿,四肢肌力、肌张力正常,病理征阴性。
外院辅助检查
血常规:

尿、粪常规:正常
肝肾功能:正常
炎症指标:CRP >200mg/L ESR: 105mm/h PCT <0.10ng/ml
D-二聚体:正常
痰抗酸染色:阴性
血培养:未见细菌生长
胸部CT:

2017-1-15

2017-1-23

2017-2-5

2017-3-5
病例总结
> 中年女性,既往体健,亚急性起病。
> 临床表现为发热、咳嗽、咳痰、胸闷,左上肺语颤稍增强,叩诊浊音,左上肺呼吸音粗,可闻及爆裂音。
> 辅助检查:血象不高,ESR、CRP显著增高,PCT正常
> 影像学检查:起病表现为右上叶后段斑片状高密度影,伴部分实变,可见支气管充气征,抗感染治疗后右上叶病灶完全吸收,新出现左上肺团片影,周边磨玻璃影,及右下肺背段不规则团块影。
中年女性,双肺病变,外院抗感染治疗效果欠佳,是考虑感染性疾病还是非感染性疾病?
感染性疾病方面,首先我们要考虑抗菌药物力度是否足够,能否覆盖致病菌,是否存在细菌耐药情况,再者考虑是否存在特殊病原体感染,如结核分支杆菌、真菌、病毒等。非感染性疾病方面需要进一步排查,完善风湿结缔组织全套、ANCA4项、淋巴细胞亚群分析等。
张永高教授
(影像与核医学科)从影像学角度解读3次胸部CT的改变可以对疾病性质有个初步的判断。
患者起病时2017-1-15胸部CT病变主要在右肺上叶后段,表现为大片状高密度影,可见支气管气象,提示支气管内不是阻塞性病变,病灶内有实变,周围有渗出性改变,纵膈窗和肺窗差别比较大,说明病灶密度不是非常高;

2017-1-23胸部CT病灶从范围来看是逐步扩大的,仍可见支气管气象,周围渗出更加明显,纵膈窗来看病灶总体密度增高,影像学表现总体提示病灶进展;

2017-2-5胸部CT:整体病变范围与2017-1-23号CT变化不大,但整体密度呈减低趋势,纵膈窗影像密度与肺窗差别较大,说明病变呈好转趋势;

2017-3-5胸部CT右上肺大片状高密度影消散,仅留下少许高密度条索影,但左肺上叶后段出现新发病变,但与之前右肺上叶病变影像学特征有所不同,之前三次影像学病灶密度是比较均匀的,此次左肺上叶后段病变,除了实变之外可见类空洞样改变,仍有支气管充气征,周围见细条索影,右下肺背段见类结节影像。
就非感染性病变ANCA相关性血管炎来说,影像学特征不是特别符合,ANCA相关性血管炎主要表现为两肺多灶性病变,沿着血管纹理走行,可见斑片影及小空洞改变,以单发的大片实变影表现并不常见。
2017-1-23病灶呈楔形改变,还要与急性肺栓塞引起的肺梗死相鉴别,但病变过程及临床检查不支持。影像角度来讲,病灶的游走性是指另一部位发生与该部位同一性质的改变,如另一部位病变与该部位性质有差异,可能是由于疾病的多态性造成的同病异影,也可能是不同性质的病变。
李芳教授
(呼吸与危重症医学科)从常见病多发病的角度来看,还是要把感染性疾病放在首位,病人有呼吸道症状,影像学改变有斑片影及渗出改变。社区获得性肺炎的常见病原体有肺炎链球菌、卡他莫拉菌及流感嗜血杆菌,患者外院曾用过阿奇霉素、左氧氟沙星、莫西沙星进行治疗,但影像学吸收是非常延迟的,用CAP有不好解释的地方,如果是个感染,病原体是否有所不同? 虽然患者社区起病,但患者有住院经历,在住院过程中不排除发生革兰氏阴性菌感染,之前用药方案主要覆盖球菌和非典型病原体,这是我们要考虑到的地方。至于特殊病原体感染,从影像学来看,不符合结核多态性的影像学特征,而且短期内没有在正规抗痨治疗的前提下右上肺病灶吸收干净,用结核不好解释。另外该病人没有宿主因素,真菌感染机会相对小,但隐球菌可以发生在正常免疫力的人群,详细追问病史患者家里及周围邻居均为饲养鸽子,在未抗真菌治疗的基础上右上肺病灶的吸收同样不好解释。另外需要排查寄生虫感染,寄生虫感染可以在肺部形成迁延不愈的影像学特点,但该患者没有生食虾蟹的情况。至于非感染性疾病需要进一步排查EGPA、嗜酸粒细胞肺炎、机化性肺炎等等。
初步诊断
社区获得性肺炎
入院初步治疗方案
抗感染治疗:头孢哌酮舒巴坦 3.0g ivgtt q8h
辅助检查结果回报
血常规:

生化:肝肾功能血糖、电解质正常
炎症指标:ESR 85mm/h,CRP 87.1mg/L;PCT 0.162ng/mL (参考值0-0.046)
凝血功能:正常
传染病四项:阴性
感染指标:G/GM试验:正常;病毒全套:EBV-IgG(+),CMV-IgG(+);T-spot:正常;支原体、衣原体抗体:阴性;寄生虫全套:囊虫、弓形虫、肺吸虫、旋毛虫抗体均为阴性
风湿免疫:ENA全套:ANA、ds-DNA、Sm、SSA、SSB抗体等均(-);ANCA四项(-) ;淋巴细胞亚群测定:正常
痰培养:阴性
血培养:阴性
痰抗酸染色:阴性
ECG:正常
腹部彩超:肝胆胰脾未见明显异常
一氧化氮呼气试验:38ppb
肺功能:肺通气功能正常、弥散功能正常、弥散量正常、肺总量正常、残气量及功能残气量正常、肺活量正常、残气/肺总量正常、乙酰胆碱激发实验阴性 FEV1下降2.3%

支气管镜检查:

气管、右主支气管及所属支气管粘膜充血,管腔内可见少量粘稠分泌物;
左上叶尖后段BAL;
于左上叶尖后段可探及异常回声区,活检、刷检并生理盐水灌洗。
支气管镜检查结果:

TBLB病理:肺组织慢性炎伴纤维组织增生,PAS(-),六铵银(-), 抗酸(-)
左上叶刷检:镜下见少量上皮细胞,少数中性粒细胞、淋巴细胞
BALF:镜下见少数中性粒细胞,个别上皮细胞
BALF培养:未见细菌生长
病情变化
经过抗感染治疗7天,患者体温正常,咳嗽、咳痰好转,间断胸闷,查体 :左上肺语颤稍增强,叩诊浊音,左上肺呼吸音粗,未闻及干、湿罗音。但2017-3-12复查胸部CT,左上肺及右下肺背段病灶无明显吸收。
2017-3-12胸部CT:

靳建军教授
(呼吸与危重症医学科)需要强调的是,病理学发现肺泡腔内有纤维素渗出不等同于机化性肺炎。纤维素渗出可以见于细菌感染、弥漫性肺泡损伤、见于OP及嗜酸性粒细胞肺炎。但该患者TBLB病理结果局部发现机化及肺泡腔内纤维素渗出,可以认定病人存在机化性肺炎。
机化是机体对损伤的一种反应,机化性肺炎是一种以肺泡腔内纤维素渗出,疏松结缔组织以及肉芽组织充填为特征的炎症性肺部疾病,根据是否有明确的病因和系统性疾病分为隐源性机化性肺炎和继发性机化性肺炎。继发性机化性肺炎可以继发于感染、结缔组织病、造血干细胞移植等多种损伤因素,临床上需要寻找继发因素。
隐源性机化性肺炎是特发性间质性肺炎的一个亚型,临床表现上难以与普通肺炎相区别,但有其独特的影像学特征,主要表现为多形性、多态性、多变性,该患者影像学特征是符合COP的。COP的病理学特征是肺泡腔内由肉芽组织充填伴有纤维素渗出,但纤维素渗出往往不超过10%。AFOP是2013年间质性肺病中提出的一种特殊的病理类型,可以分为特发性和继发性,继发因素与SOP相似,特发性又分为2类,急性与亚急性,急性的发病迅速,很快进展至呼吸衰竭,亚急性在病程在病程上类似OP,但亚急性AFOP是否是一种独立的疾病,很多学者还存在争议。GOP是一种新近发现的机化性肺炎,同样以肺泡腔机化为主,但肺泡腔内炎症细胞以淋巴细胞和浆细胞浸润为主,在临床上更为罕见。间质性肺疾病的诊断依赖于临床、影像、病理多学科协作,该病人临床特点及影像学特征符合COP与亚急性AFOP,但定性需要依赖病理学对肺泡腔内纤维素渗出比例的判读,如纤维素渗出比例小于10%,在排除继发因素的前提下,可考虑COP;如纤维素比例超过50%,甚至形成纤维素球,则考虑AFOP可能性大,结合患者病程特点亚急性起病,则考虑亚急性AFOP。
李道明教授
(病理科)患者肺穿刺病理结果与TBLB病理结果还是有很大区别,TBLB病理结果最突出的病变是间质性肺炎,肺泡里面有少量红染的纤维素样渗出物,而右下肺穿刺病理结果间质性肺炎不明显,肺泡壁增厚不明显,最突出的病变为肺泡腔内大量红色纤维素样渗出物,有些通过肺泡间孔相连,切片上有些地方镜下可见纤维母细胞和肌纤维母细胞增生(即肉芽组织)以及炎症细胞浸润。

肺穿刺的病理结果诊断机化性肺炎是没有问题的。机化性是病理现象,不能作为一种独立性疾病进行诊断,是疾病伴发的一种现象。SOP和COP镜下较难区分,但AFOP和COP的区别则主要看纤维素渗出的量,该患者肺穿刺病理从整体切片来看纤维素渗出的量在30~50%之间,未见多核巨细胞及中性粒细胞及嗜酸性粒细胞浸润,以少量淋巴细胞及少量单核细胞浸润为主。综上所诉,诊断AFOP较为合理,同时需进一步结合临床。
苗丽君教授
(呼吸与危重症医学科)经过临床、影像与病理综合分析,该患者最终诊断为亚急性纤维素性机化性肺炎。AFOP是2013年由美国胸科协会与欧洲呼吸协会发布的特发性间质性肺疾病的一个类型,发病年龄通常在50-70岁,男性发病率略高于女性,可分为特发性和继发性,临床表现可出现全身性及呼吸系统症状,病人可出现发热、胸闷、呼吸困难、咯血等。该病临床类型分为急性爆发型和亚急性2种类型,急性爆发型病情进展迅速,病人很快进展至ARDS,平均死亡时间为29天,死亡率高达90%。亚急性型病程大于2个月,该病人临床特点符合亚急性,亚急性预后较好,影像学表现可表现为多发斑片影、渗出影,结节影、可出现游走性,类似于COP影像学特点,但最终要有赖于病理诊断。AFOP病理学特征为肺泡腔出现纤维素沉积,无肉芽肿形成,无透明膜形成,无嗜酸粒细胞浸润,这一点需要与COP鉴别。OP的病理学特征为肺泡腔内可见肉芽肿形成,即肌纤维细胞和成纤维细胞,该点要与AFOP进行鉴别。
吴秋歌教授
(呼吸与危重症医学科)该病人诊断亚急性AFOP明确,针对AFOP的治疗,国内外现有的指南以及资料暂无统一治疗标准,但目前公认糖皮质激素是AFOP的主要治疗药物,不论是特发性还是继发性因素引起的。特发性AFOP治疗需根据病情严重程度来选择治疗药物。目前治疗AFOP主要有三大类药物:第一类是糖皮质激素,第二类是免疫*制剂抑**,第三类是免疫球蛋白,以及支持治疗包括机械通气及ECMO。急性爆发性AFOP,病人病情重,短期内发展为呼吸衰竭,死亡率高,这种情况可选择激素冲击治疗,最大量可不超过1000mg/d,治疗时间长短及减量方案需要结合病人对药物的反应,病人年龄及恢复情况来综合判断。另外需要注意糖皮质激素的副作用,比如继发感染的问题、骨质疏松以及胃肠道粘急性病变以及肌病的问题。亚急性AFOP激素的选择也需要结合病人年龄、基础疾病的情况以及肺部病变严重程度来个体化定制治疗方案。激素需要静脉和口服序贯治疗,根据病人恢复情况规律减量。另外,继发性AFOP不要忽视原发病的治疗。

王静教授点评
该患者病情一波三折,该患者诊断亚急性AFOP明确,而且使用糖皮质激素后病灶明显吸收,病程转归是令人欣慰的。但我们在治疗过程中也有需要进一步完善的地方,比如说BALF要送细胞学分类,BALF对疾病的预测价值我们临床大夫要提高重视,同时要加强对病人的追踪随访。另外,多学科协作对病情诊断和治疗上都有很大指导意义。作为一名临床医生,不但要注重病人病史、临床表现、体格检查、实验室检查,还要对治疗经过做一个完整的梳理,病情诊断需要临床病理相结合,比如COP、SOP、AFOP有时从临床表现上难以区分,这时就需要我们从病理上进一步甄别。
作者介绍

伍冬冬
医学博士,主治医师,河南省呼吸与危重症学会间质性疾病分会委员。熟练掌握呼吸危重症的救治,擅长呼吸系统常见病的诊疗。
本文完
编辑:《呼吸界》Jerry
未经许可,请勿转载